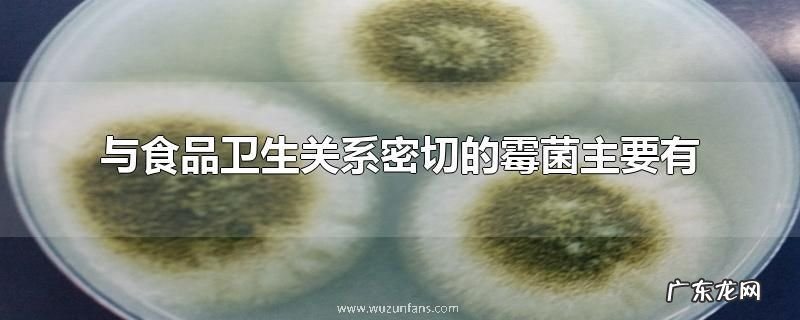

【与食品卫生关系密切的霉菌主要有】 与食品卫生关系密切的霉菌主要有曲霉菌属、青霉菌属和镰刀菌属 。霉菌是真菌的一种,其特点是菌丝体较发达,无较大的子实体 。同其他真菌一样也有细胞壁,以寄生或腐生方式生存 。霉菌是形成分枝菌丝的真菌的统称 。
与食品卫生关系密切的霉菌主要有
文章插图
霉菌是丝状真菌的俗称,意即“发霉的真菌”,它们往往能形成分枝繁茂的菌丝体,但又不像蘑菇那样产生大型的子实体 。
霉菌有的会使食品转变为有毒物质,有的可能会在食品中产生毒素,即霉菌毒素,对人体健康造成的危害极大 。
影响霉菌生长繁殖及产毒的因素是很多的,与食品关系密切的有水份、温度、基质和通风等条件 。因此,控制这些条件可以对食品中霉菌的分布及产毒造成很大的影响 。
(⊙_⊙;)
- 圣诞节与八国联军侵略中国有关吗
- 花椒芽的功效与禁忌
- 黄酒的功效与作用、禁忌和食用方法
- 嫂和自己关系是什么
- 柳叶茶的功效与禁忌
- 普洱熟茶的功效与作用
- 斑马豆的功效与作用及食用方法
- 我国与几个国家海上相邻或者相向
- 香椿的功效与禁忌
- 柠檬酒的功效与禁忌
特别声明:本站内容均来自网友提供或互联网,仅供参考,请勿用于商业和其他非法用途。如果侵犯了您的权益请与我们联系,我们将在24小时内删除。
